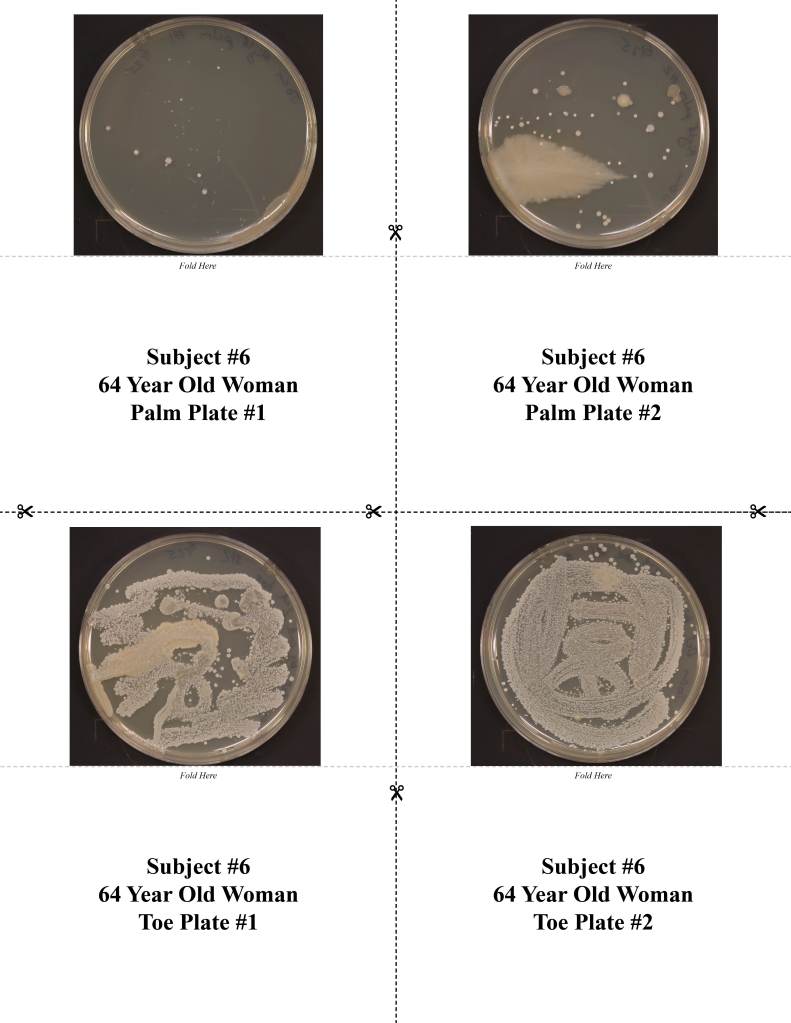

In this activity, undergrads had people form hypothesis about different parts of the human microbiome. They then used photos of plates from those microbiomes to get people to test their hypotheses. Below are some sample images and the paper.

In this activity, undergrads had people form hypothesis about different parts of the human microbiome. They then used photos of plates from those microbiomes to get people to test their hypotheses. Below are some sample images and the paper.